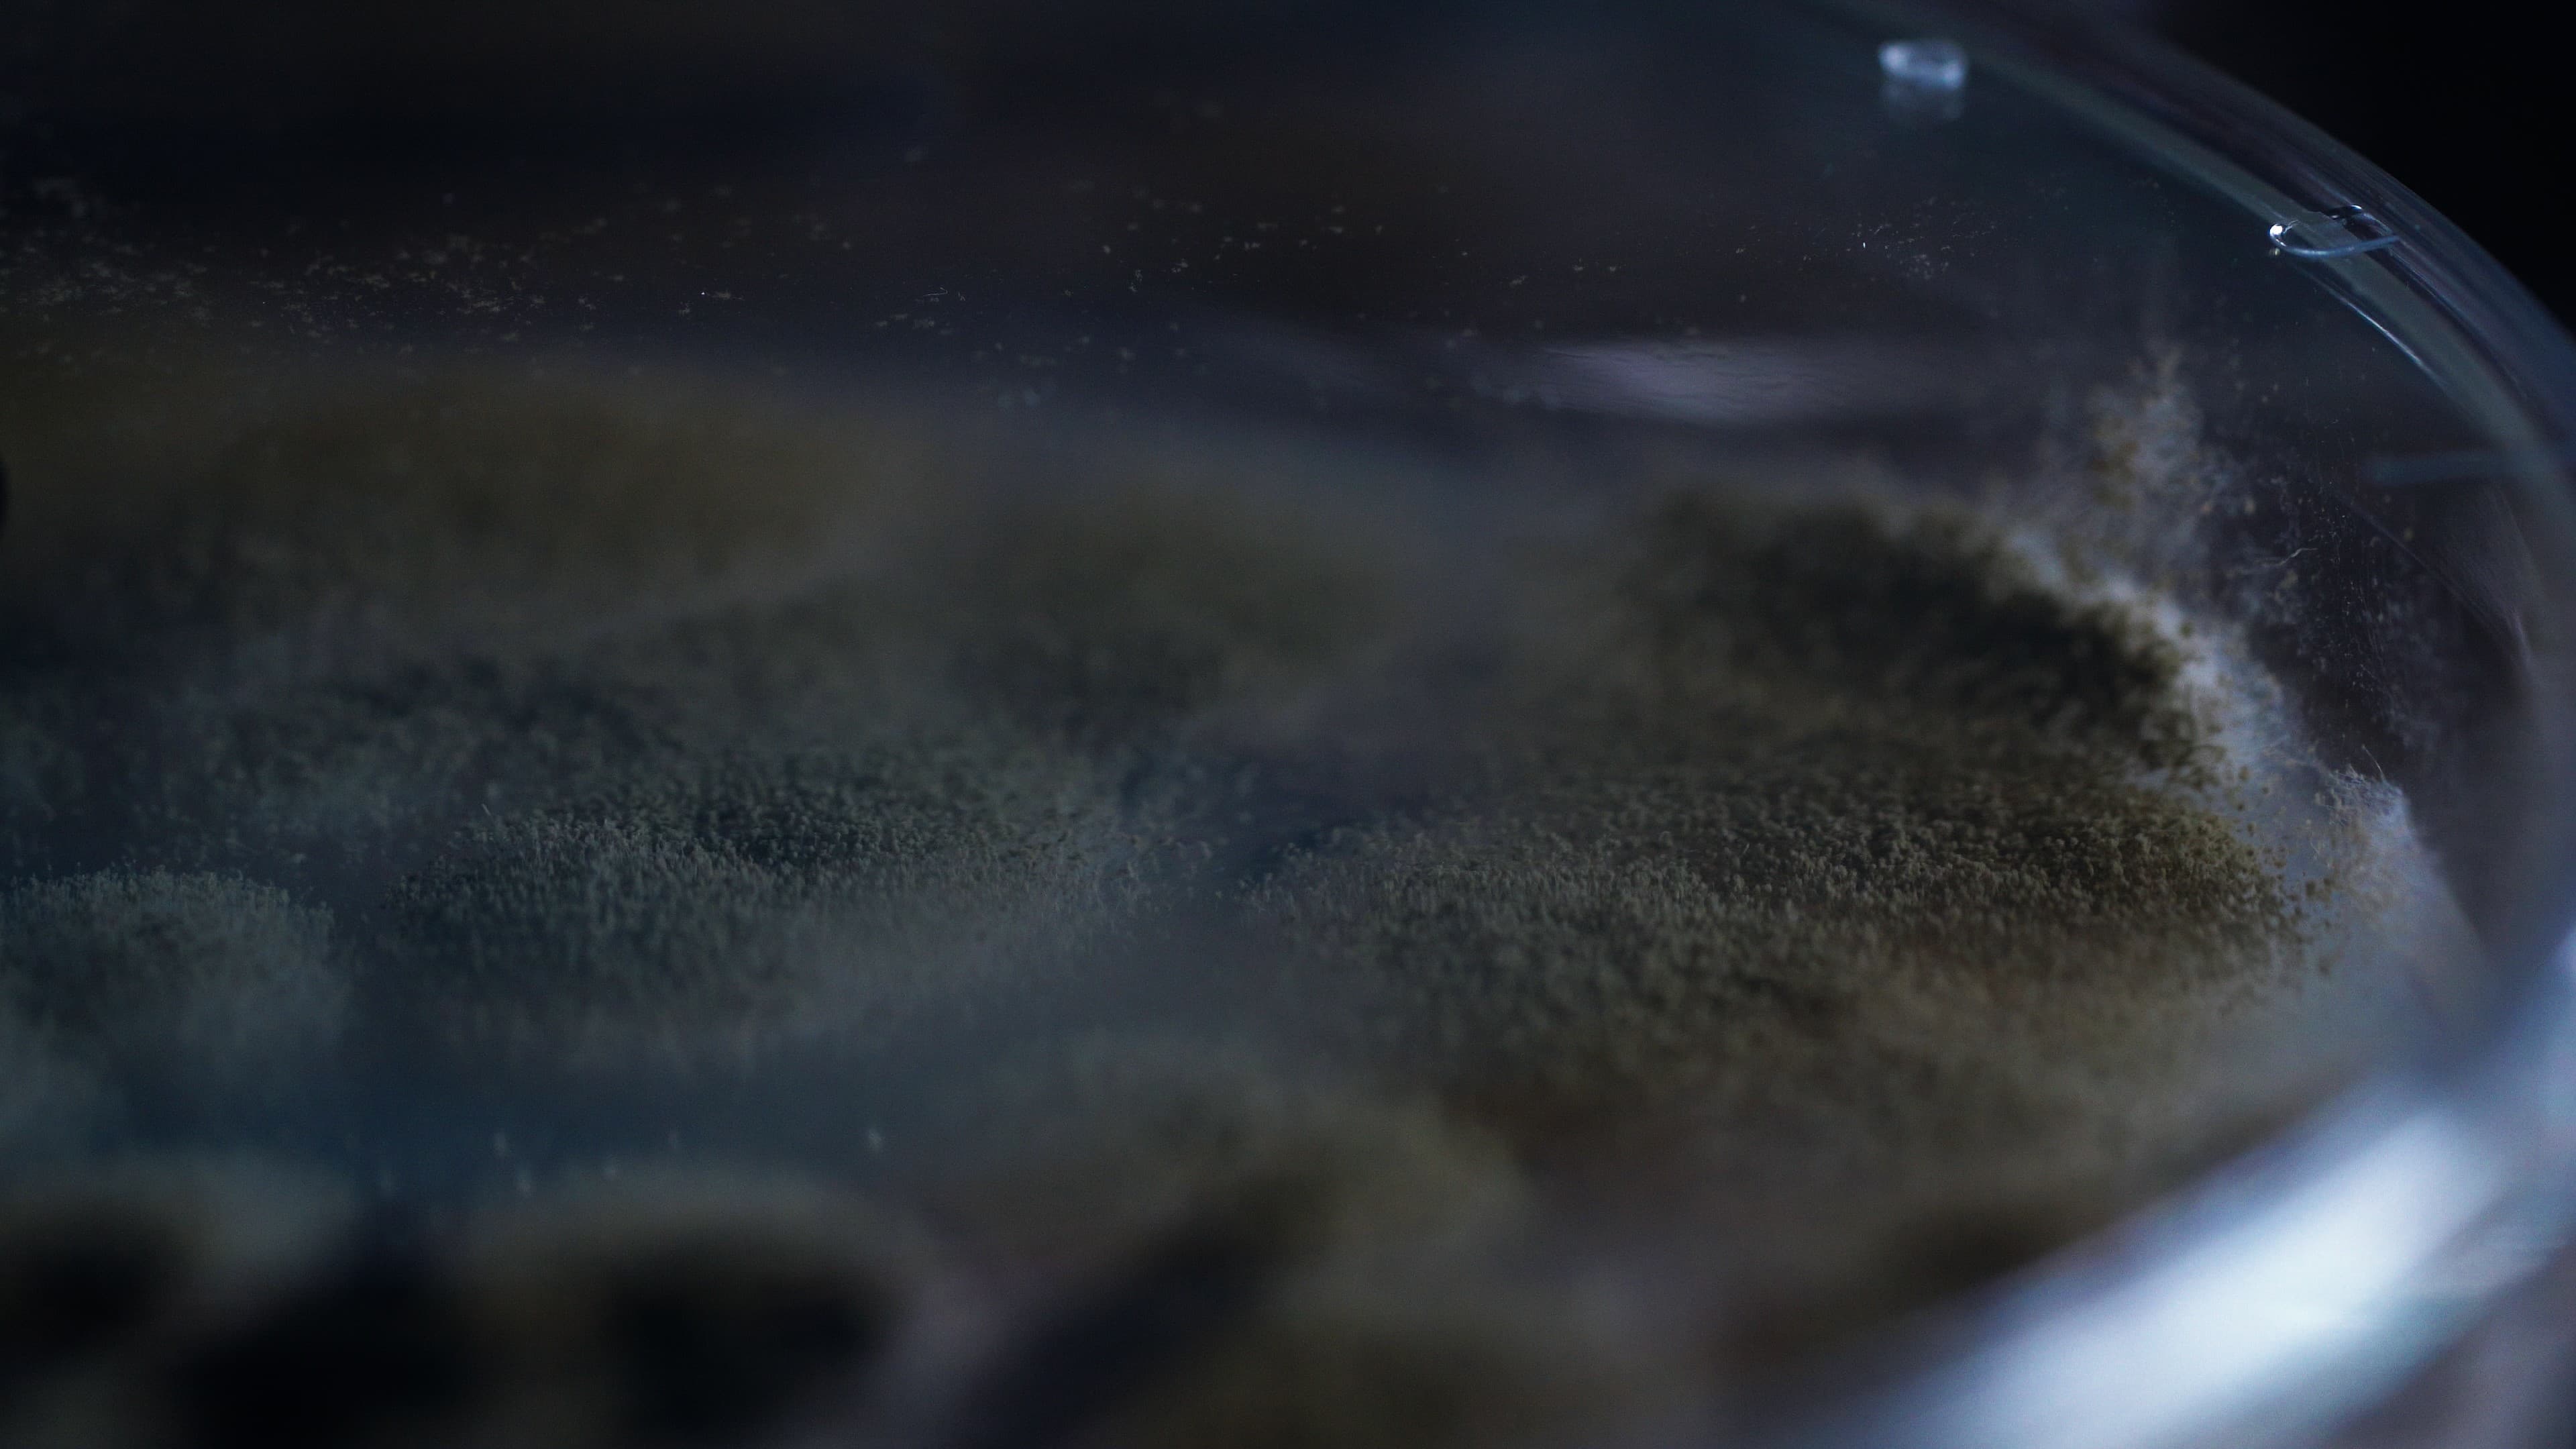
FAS

向山はじめに、自己紹介をお願いできますでしょうか。
佐藤株式会社秋田今野商店の佐藤勉です。酒・味噌・醤油・焼酎に代表される日本の発酵食品の要である麹の種菌を製造・管理をしています。
ーーーー明治10年、秋田県刈和野村(かりわのむら)で醤油醸造を家業としていた今野家は、京都で「醸造材料商今野商店」を設立。その後、太平洋戦争による原料事情の悪化に伴い、米どころである秋田の地で事業を再開。株式会社秋田今野商店となる。
向山ありがとうございます。日本の発酵文化を支えつづけてきた秋田今野商店様。その中で佐藤さんはどのような役割を担われてきたのでしょうか。
佐藤主に種麹の研究に尽力しております。発酵や菌の研究をしていると言うと、何か新しいものを開発しているんじゃないかとイメージされる方が多いと思います。確かに新しいものを生み出すことも役割の一つですが、それだけではなく「菌を大切に守り、変わらないように正しく継承していく」ことも役割の一つです。
ーーーー先人たちが見つけつないできたものを、未来に変わることなく継承していく。100年以上菌と向き合いつづけてきた秋田今野商店には、受け継がれてきた様々な菌と考え方がある。
向山先人たちの手によって受け継がれてきた菌たちですが、秋田今野商店様では今どのくらいの菌を保有しているのでしょうか。
佐藤ざっくりとにはなってしまいますが、一万株以上は保有しているかと思います。
向山一万株……すごい数ですね!!
株数、あまり聞き慣れない言葉ですが菌の種類の量を表す数え方なのでしょうか。
佐藤種類とは少し異なります。人間と同じで、日本人という系統(人種)は同じでも、一人ひとりには個性があってできることが変わる。菌も同じで、同じ系統(名前)の菌だとしても、それぞれ顔つきが異なり、できることが変わる。それらを識別して分けた時の単位が株と呼ばれるものです。
ーーーー菌株(きんかぶ)とは、同じ菌種に属する微生物の集団で、特定の遺伝子型を共有する個体群を指す。
向山株ごとに顔つきが異なる。素人目からしたら同じに見えてしまいそうですが、どのように見分けられているのでしょうか。
佐藤目視で微生物が生育した時の形態等をしっかりと観察して識別します。それに加えて、有機酸や酵素力価などを分析した結果も加えて選定します。
佐藤目視じゃないとわからないこともあります。拡大して写真をとって確認をすることもありますが、それだけでは違いがわからないこともある。菌一つひとつに向き合うだけじゃなくて、人間の目ぐらい引いた視点でコロニー(集合体)として観察する。シャーレを上からみるだけじゃなくて、裏からも観察したりする。そうすると、コロニーの盛り上がり方だったり、質感がマットだったり、写真には映らないものをみることができます。
向山なるほど。様々な角度から菌に向き合うということですね。
菌に向き合うという点でいえば、「菌を大切に守り、変わらないように正しく継承していく」ことも大切な役割だとお伺いしました。そのお話からそれだけ菌の変化が早いということがわかりますが、菌の変化にいち早く気づくために心掛けていることはありますか。
佐藤毎日出勤して机に座る。その前に必ず菌のヒアリングを行うことを大切にしています。先ほど、目視で菌を確認するというお話をさせていただきましたが、菌の状態を確認する方法は他にもいくつかあります。例えば「触感」で菌の状態をみる。菌が入っている容器をかき混ぜた時にドロドロなのかサラサラなのか、抵抗感があるのか、ないのか。極端な話、ラボの扉を開けて入った時の匂いでも菌の変化を確認することができたりします。いつもと違う匂いがすると感じた場合は異常発酵をしている可能性がある。数値で確認することはもちろん大切なことですが、それだけではなくて人間の五感で菌の状態を確認することも、菌の変化に素早く気づくためには大切なことだと考えています。
向山FASの製品は白米ではなく黒米が原料となっていますが、お米の違いにより菌に与える影響は異なるのでしょうか。
佐藤黒い米だとそこに含まれるアントシアニンが、菌に負荷をかけます。負荷が加わるとそこから生まれてくるものも変わってくる。負荷をかけるという点でいえば温度変化によっても負荷をかけることができます。
向山それぞれの菌によって適温があり、あえてその温度を変化させ、菌に負荷をかけるということでしょうか。
佐藤おっしゃる通りです。実際に酵母を培養しようと思うと大体30度前後で温度管理を行うことが一般的ですが、日本酒づくりなどの環境を見ていると寒い時期に行われている。つまり、負荷をかけているということです。負荷をかけないと理想とする香りが出なかったり、アルコールを生んでくれなかったりする。人間にとって都合の良いものをつくってもらうためには、負荷をかけて頑張ってもらう必要があります。
向山菌に向き合うということは、些細な変化に向き合いつづけることだと、お話を伺って感じました。一つひとつの事象に向き合いつづけることは、それだけ体力がいることだと思います。日々、菌に向き合いつづける佐藤さんの原動力をお伺いできますか。
佐藤興味があるんですよね。単純に菌は面白い。
大きな発見がいつもあるわけではないですが、小さな発見に日々出合うことができる。菌が入った容器を少し振ってみるとか、少し行動を変えてみるだけで結果が変わる。いつも菌に向き合っているからこそ見つけることができる違いがあって、そこが面白いところです。
そして、そんな風に変わりつづけることがベースにある菌ですが、先人たちはそれを100年以上守り継承してきています。しかも一万株も。それってとてもすごいことじゃないですか。先人たちが発見してつないできたものを、未来につないでいきたい。つないでいく使命が僕にはあると思っています。
Profile
株式会社秋田今野商店 生産・技術部長 佐藤 勉
日本の発酵文化を支える老舗麹メーカー「秋田今野商店」の生産・技術部長およびバイオインキュベーションセンター長を務める。種麹や酵母菌の研究・開発に長年携わり、伝統的な発酵技術と最新のバイオ技術を融合させ、日本の発酵文化の発展に寄与している。